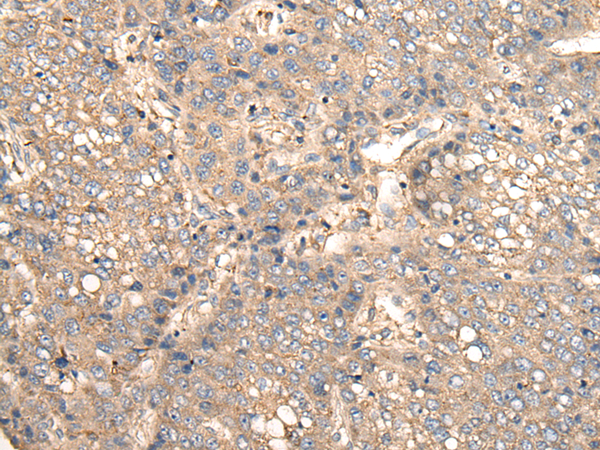
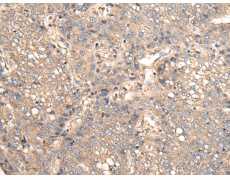
一抗

WB Recommended dilution:
500-2000
WB Positive control:
Human kidney tissue,RAW264.7 cell,Mouse kidney tissue,Human lung tissue,Human fetal liver tissue,Hela and 231 cell lysates
WB Predicted band size:
27 kDa
IHC Recommend dilution:
25-100
IHC positive control:
Human liver cancer and human esophagus cancer
ELISA Recommended dilution:
5000-10000
SwissProt:
Q9UEU0
Synonyms:
VTI1; VTI2; VTI1L; v-SNARE; vti1-rp1; VTI1-LIKE
Full name:
vesicle transport through interaction with t-SNAREs 1B
Immunogen:
Full length fusion protein
Name of antibody:
VTI1B
Applications:
ELISA, WB, IHC
Background:
V-SNARE that mediates vesicle transport pathways through interactions with t-SNAREs on the target membrane. These interactions are proposed to mediate aspects of the specificity of vesicle trafficking and to promote fusion of the lipid bilayers. May be concerned with increased secretion of cytokines associated with cellular senescence.

購物車
購物車 幫助
幫助
 021-54845833/15800441009
021-54845833/15800441009